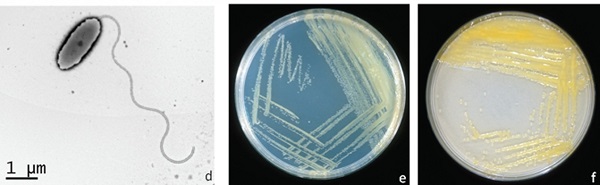
xanthomonas-campestrippv-cv-gay-benh-ri-dom-mat-cua-sau-rieng

Đối với người dân trồng sầu riêng có lẽ sẽ không còn xa lạ gì với căn bệnh đốm mắt cua. Căn bệnh này gây ảnh hưởng trực tiếp đến sự phát triển của cây và cần phải phát hiện kịp thời, tìm ra cách chữa trị đúng đắn để giúp cây phục hồi và phát triển bình thường. Dù là căn bệnh quen thuộc nhưng có không ít người dân vẫn chưa tìm ra được biện pháp điều trị. Vậy thì hãy cùng phanthuocvisinh.com theo dõi bài viết này để biết được cách trị bệnh đốm mắt cua trên cây sầu riêng nhé!

Contents
Bệnh đốm mắt cua trên cây sầu riêng là căn bệnh phổ biến. Nó gây ảnh hưởng xấu đến sản lượng cũng như chất lượng của sầu riêng. Chính vì vậy, khi trồng loại cây này bà con cần quan sát kĩ lưỡng. Nhìn nhận một số dấu hiệu sau đây để phát hiện cây đang mắc bệnh và nhanh chóng chữa trị.

+ Ban đầu trên vùng lá cây sẽ xuất hiện những đốm nhỏ màu vàng nhạt. Ví dụ như vết kim châm và thường hay gặp ở những chiếc lá non. Trải qua một thời gian những vết đó sẽ dần chuyển sang màu nâu nhạt. Kích thước to, nhỏ của những vết bệnh còn phụ thuộc và giống cây sầu riêng.
+ Khác với những căn bệnh khác, đốm mắt cua hại sầu riêng lại không làm cho lá biến dạng. Nó chỉ làm xuất hiện những vết bệnh trên cả 2 mặt của lá. Bao bọc xung quanh sẽ là đường viền màu vàng sáng.
Khi quả bị loại nấm hại tấn công chúng sẽ bị xuất hiện những đốm đen theo từng vùng. Thậm chí, nấm còn bao vây toàn bộ quả. Những vết nấm bệnh xù xì, màu nâu đen, ở viền ngoài có gờ nổi lên. Còn ở giữa lại có mô chết rạn nứt. Nếu không được chữa trị kịp thời, bệnh thêm nặng sẽ làm cho quả bị biến dạng, khô lại, ít nước và nhanh rụng.
Dựa vào những dấu hiệu trên, bà con nông dân hãy chú ý phát hiện bệnh sớm để áp dụng biện pháp chữa trị, không làm ảnh hưởng đến chất lượng của cây.
Bệnh đốm mắt cua hại sầu riêng hay còn gọi là bệnh rỉ sắt trên cây sầu riêng. Bệnh này do vi khuẩn Xanthomonas campestricpv.cv gây ra.
Trên thực tế, vi khuẩn này sẽ phát sinh trong điều kiện nhiệt độ cao từ 20 đến 30 độ C. Đặc biệt là trong những khu vườn, trang trại trồng cây với mật độ quá dày, rậm rạp, không thoáng đãng, thiếu tiếp xúc với ánh sáng, không có sự chăm sóc thường xuyên của con người.
Bệnh có thể lây lan qua nhiều con đường khác nhau như: gió, mưa, con người, động thực vật, dụng cụ làm vườn,… gây hại cho nhiều cây non, lá non.
Các loại côn trùng khi tấn công cây sầu riêng sẽ để lại các vết xước. Đó cũng là nguyên nhân để cho bệnh đốm lá cua dễ dàng xâm nhập vào trong các tế bào của cây và gây ra những ảnh hưởng xấu.
Sầu riêng bị đốm mắt cua có tốc độ lây lan vô cùng nhanh chóng. Đặc biệt là trong điều kiện trời mưa bão. Vì vậy bà con cần phải phát hiện sớm thực hiện các biện pháp phòng ngừa và chữa trị. Từ đó không gây ảnh hưởng đến quá trình sinh trưởng và phát triển của sầu riêng.

Trong quá trình phát triển của cây sầu riêng, bà con cần nhận ra một số dấu hiệu của bệnh. Sau đó cần phải nhanh chóng tiêu huỷ, dọn dẹp sạch sẽ vùng bị vi khuẩn tấn công để không thể lây lan sang các cây xung quanh.
Tăng sức đề kháng cho cây: cung cấp đầy đủ chất dinh dưỡng cho cây thông qua việc bón các loại phân đa, trung vi lượng. Bổ sung chất bổ dưỡng vi lượng thông qua lá phụ thuộc vào sự phát triển của cây. Góp phần làm tăng sức đề kháng cho sầu riêng. Không để cây thiếu đi nguồn dinh dưỡng đặc biệt là giai đoạn ra quả non.
Ngoài các biện pháp trên, bà con có thể sử dụng thuốc trị bệnh đốm mắt cua cho cây sầu riêng Vaccino CAN – trừ nấm bệnh sinh học. Để sử dụng, bạn chỉ cần hòa 25 – 50ml thuốc với 200 lít nước. Sau đó đem phun 2 – 3 lần mỗi lần cách nhau 3 – 5 ngày lên vùng cây bị vi khuẩn. Điều đó sẽ làm tiêu diệt nấm bệnh, giúp cây phát triển khoẻ mạnh, tăng cường đề kháng, hạn chế mắc phải các căn bệnh thông thường khác.
Để có thể mua được thuốc Vaccino CAN chính hãng mà không nhầm với các loại thuốc giả đang tràn lan, mất kiểm soát trên thị trường, bà con hãy liên hệ ngay tới hotline 09622 41 635 để được CÔNG TY TNHH CÔNG NGHỆ SẠCH NÔNG NGHIỆP hướng dẫn chi tiết cách sử dụng và mua hàng chính hãng nhé.
Vậy là ở bài viết trên, Phân thuốc vi sinh AT đã chia sẻ đến cho các bạn độc giả những nguyên nhân, triệu chứng cùng những biện pháp ngăn ngừa và chữa trị bệnh đốm mắt trên cây sầu riêng. Mong rằng qua những chia sẻ trên sẽ giúp đỡ được phần nào cho bà con trong quá trình trồng sầu riêng.
Giỏ hàng của bạn hiện tại chưa có sản phẩm nào.

